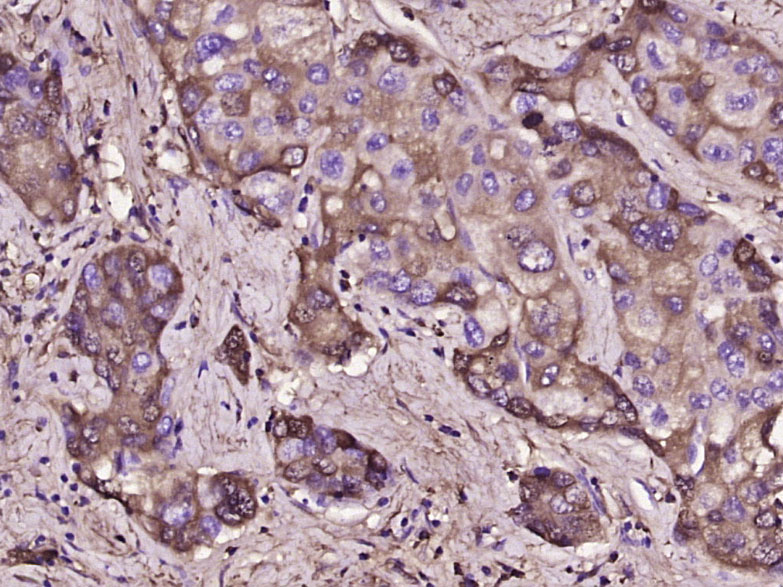
产品细节图片1

相关产品推荐更多 >

CD56 Rabbit pAb, Cy7 conjugated(bs-0805R-Cy7)-100ul
¥2980
GADD45B Rabbit pAb, APC-Cy5.5 conjugated(bs-5904R-APC-Cy5.5)-100ul
¥2980
alpha Sarcoglycan Rabbit pAb(bs-8740R)-50ul/100ul/200ul
¥1180
TCL3/HOX11 Rabbit pAb(bs-17360R)-50ul/100ul/200ul
¥1180
IRAK1 Rabbit pAb, HRP conjugated(bs-28003R-HRP)-100ul
¥2980
万千商家帮你免费找货
0 人在求购买到急需产品
- 详细信息
- 文献和实验
- 技术资料
- 应用范围:
产品信息以Bioss网站为准
- 规格:
50ul/100ul/200ul
| 规格: | 50ul | 产品价格: | ¥1180.0 |
|---|---|---|---|
| 规格: | 100ul | 产品价格: | ¥1980.0 |
| 规格: | 200ul | 产品价格: | ¥2800.0 |
| 产品编号 | bs-3514R |
| 英文名称 | D-DIMER Rabbit pAb |
| 中文名称 | 交联纤维蛋白二聚体抗体 |
| 英文别名 | Fibrinopeptide A; Fibrinogen alpha chain; |
| 产品应用 | IHC-P=1:100-500, IHC-F=1:100-500, IF=1:100-500 Not yet tested in other applications. |
| 交叉反应 | Human |
| 抗体来源 | Rabbit |
| 免疫原 | homogenized human fibrin clot |
| 亚型 | IgG |
| 性状 | Liquid |
| 纯化方法 | affinity purified by Protein A |
| 克隆类型 | Polyclonal |
| 理论分子量 | 340 kDa |
| 浓度 | 1mg/ml |
| 储存液 | 0.01M TBS (pH7.4) with 1% BSA, 0.02% Proclin300 and 50% Glycerol. |
| 亚基 | Heterohexamer; disulfide linked. Contains 2 sets of 3 non-identical chains (alpha, beta and gamma). The 2 heterotrimers are in head to head conformation with the N-termini in a small central domain. |
| 亚细胞定位 | Secreted. |
| 组织特异性 | Plasma. |
| 翻译后修饰 | The alpha chain is not glycosylated.
Forms F13A-mediated cross-links between a glutamine and the epsilon-amino group of a lysine residue, forming fibronectin-fibrinogen heteropolymers. About one-third of the alpha chains in the molecules in blood were found to be phosphorylated. Conversion of fibrinogen to fibrin is triggered by thrombin, which cleaves fibrinopeptides A and B from alpha and beta chains, and thus exposes the N-terminal polymerization sites responsible for the formation of the soft clot. The soft clot is converted into the hard clot by factor XIIIA which catalyzes the epsilon-(gamma-glutamyl)lysine cross-linking between gamma chains (stronger) and between alpha chains (weaker) of different monomers. Phosphorylation sites are present in the extracellular medium. |
| 相似性 | Contains 1 fibrinogen C-terminal domain. |
| 功能 | Fibrinogen has a double function: yielding monomers that polymerize into fibrin and acting as a cofactor in platelet aggregation. |
| 保存条件 | Shipped at 4℃. Store at -20℃ for one year. Avoid repeated freeze/thaw cycles. |
| 注意事项 | This product as supplied is intended for research use only, not for use in human, therapeutic or diagnostic applications. |
| 背景资料 | Fibrinogen is the main protein of blood coagulation system. It is a large protein and it consists of two identical subunits that contain three polypeptide chains: alpha, beta and gamma. All chains are connected with each other by a number of disulfide bonds. Fibrinopeptides A (1 to 16 amino acids) and B (1 to 17 amino acids) are released by thrombin from the N terminal parts of alpha and beta chains, respectively. In this way fibrinogen is converted into fibrin, which by means of polymerization forms a fibrin clot. Fibrinogen clotting underlies pathogenesis of MI, thromboembolism and thromboses of arteries and veins, since fibrin is the main substrate for thrombus formation. Fibrinogen activation is also involved in pathogenesis of inflammation, tumor growth and many other diseases. The normal fibrinogen concentration in plasma is about 3 mg/ml. The elevated level of fibrinogen in patient's blood is regarded as an independent risk factor for cardiovascular diseases. An increase in blood fibrinogen concentration was shown to be a strong predictor of coronary heart disease (Sonel A. et al, and Rapold H.J. et al). All these facts make fibrinogen an important parameter in the diagnosis of cardiovascular diseases. |
| 应用 | 推荐稀释比例 |
| {IHC-P} | {1:100-500} |
| {IHC-F} | {1:100-500} |
| {IF} | {1:100-500} |

风险提示:丁香通仅作为第三方平台,为商家信息发布提供平台空间。用户咨询产品时请注意保护个人信息及财产安全,合理判断,谨慎选购商品,商家和用户对交易行为负责。对于医疗器械类产品,请先查证核实企业经营资质和医疗器械产品注册证情况。
文献和实验[IF={{ 7.666 }}] {Magdalena Kopytek. et al. PAI-1 Overexpression in Valvular Interstitial Cells Contributes to Hypofibrinolysis in Aortic Stenosis. CELLS-BASEL. 2023 Jan;12(10):1402} {IF} {Human}
[IF={{ 4.2 }}] {Xinxin Li. et al. A one-step process for multi-gradient wettability modification on a polymer surface. ANALYST. 2024 Feb;:} {Other} {}
[IF={{ 3.9 }}] {Jung-Wook Song. et al. High-Dose Tranexamic Acid Enhances Circulating Neutrophil Extracellular Traps and Thrombus in Thrombosis Mouse Model. BIOMEDICINES. 2025 Jun;13(6):1284} {IHC} {Mouse}
= NAL), appears to form upon oxidative cyclization of the nonfluorescent 2:1 lysine-HNE Michael adduct-Schiff base cross-link (Scheme 1). Polyclonal antibody (PAb) to the NAL-HNE fluorophore was raised in rabbit and found to be highly specific
GE Healthcare Benzamidine Sepharose™ 6B is p-aminobenzamidine covalently attached to Sepharose 6B by the epoxy coupling method. p-Aminobenzamidine (PAB), is a synthetic inhibitor of trypsin-like serine protease. Trypsin and trypsin
/96T 2000/3000 进口分装 F0021 骨成型蛋白-9(BMP-9) ELISA 48T/96T 2000/3000 进口分装 F0022 BMP-R1A ELISA 48T/96T 2000/3000 进口分装 F0023 BMP-R2 ELISA 48T/96T 2000/3000 进口分装 F0024 BTC ELISA 48T/96T 2000/3100 进口分装 F0030 CAE-Ab ELISA 96
技术资料暂无技术资料 索取技术资料






